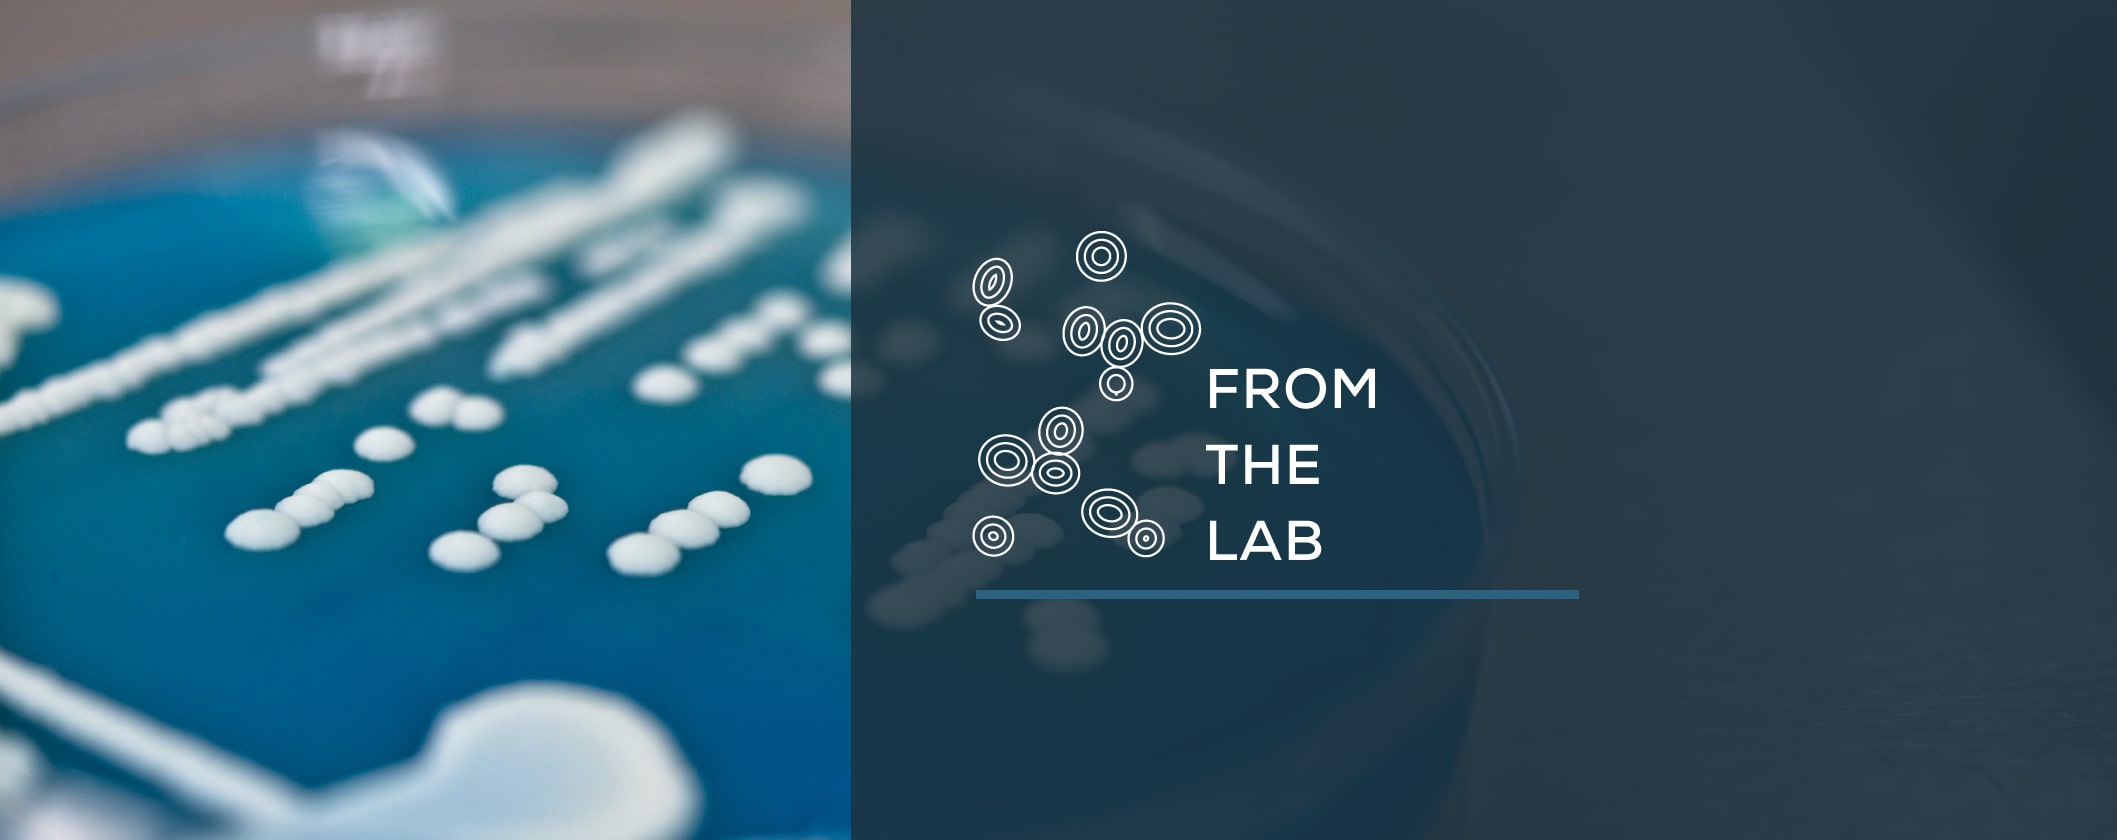
HOMEBREWING TIPS

Brew Like the Professionals
Activator Smack-Pack System™
Why brew with the Activator System™?
For 35 years, the Wyeast Activator™ is the only product that “proofs” the yeast and shortens lag time when it hits your wort. Activator™ packages include an internal packet which, when smacked, releases its contents into the yeast slurry and revitalizes the cells. The available sugars and nutrients initiate the culture’s metabolism which in turn generates CO₂ and causes swelling of the package, serving as a viability and vitality test as well. Although beneficial, cultures do not need to be activated prior to inoculation.
Key Activator™ features
Activator™ packages contain a minimum of 100 billion live yeast cells in a liquid slurry. This yeast slurry is packaged in an optimum condition for storage, while maintaining the ability for rapid and complete fermentation. The reliable cell count of all Wyeast yeast ensures that you are pitching the same amount of yeast every time while avoiding the issues that arise with over- and under-pitching.
-
For Beer
One Activator™ package is designed for direct inoculation of 5 gallons (19 L) of standard gravity ale wort – the same pitch rate used by professionals. For lagers, we recommend inoculating the wort at warm temperatures (65-72 °F, 18-22 °C), waiting for signs of fermentation, and then adjusting to the recommended temperature for the strain. Alternatively, for pitching into cold conditions (34-58 °F, 1-14 °C) or higher gravity wort, we recommend increasing this pitching rate. This can be achieved by pitching additional Activator™ packages or by making a starter culture.
-
For Wine
One Activator™ package is designed for direct inoculation of 6 gallons (22 L) of must, the same pitch rate used by professionals. We recommend inoculating at warm temperatures (70-75 °F, 21-24 °C), waiting for signs of fermentation, and then adjusting to the recommended temperature for the strain. For higher gravities, we recommend increasing this pitching rate. This can be achieved by pitching additional Activator™ packages or by making a starter culture.
-
For Malolactics
The Malolactic bacteria package contains 125 mL of slurry and is designed for direct inoculation of 6 gallons (22 L) of must or wine. Our malolactic cultures will provide rapid and complete malic acid reduction in high acid wines, which will balance and soften wine while enhancing flavor and aroma characteristics. We recommend bringing these cultures to ambient temperature before pitching. Malolactic conversion is generally completed within 1-3 months.
-
For Mead
One Activator™ package is designed for direct inoculation of 5-6 gallons (19-22 L) of must, the same pitch rate used by professionals. We recommend inoculating at warm temperatures (70-75 °F, 21-24 °C), waiting for signs of fermentation, and then adjusting to the recommended temperature for the strain. For higher gravities, we recommend increasing this pitching rate. This can be achieved by pitching additional Activator™ packages or by making a starter culture.
-
For Cider
One Activator™ package is designed for direct inoculation of 5-6 gallons (19-22 L) of must, the same pitch rate used by professionals. We recommend inoculating at warm temperatures (70-75 °F, 21-24 °C), waiting for signs of fermentation, and then adjusting to the recommended temperature for the strain. For higher gravities, we recommend increasing this pitching rate. This can be achieved by pitching additional Activator™ packages or by making a starter culture.
-
For Saké
One Activator™ package is designed for direct inoculation of 5-6 gallons (19-22 L) of seed mash, the same pitch rate used by professionals. We recommend inoculating at warm temperatures (70-75 °F, 21-24 °C), waiting for signs of fermentation, and then adjusting to the recommended temperature for the strain. For higher gravities, we recommend increasing this pitching rate. This can be achieved by pitching additional Activator™ packages or by making a starter culture.
-
For Wild & Sour
The Brettanomyces and Lactic Acid Bacteria culture packages contain 100 mL of slurry. This provides the direct pitching rate recommended for a 5 gallon (19 L) batch size. These cultures are best used at temperatures of 68 °F (20 °C) or higher. Cultures may take between 1-12 months to produce desired effects. Cultures may be inoculated anytime during primary fermentation. For accelerated results, time inoculation at the beginning of primary fermentation.
-
For Spirits
One Activator™ package is designed for direct inoculation of 5-6 gallons (19-22 L) of wort. We recommend inoculating at warm temperatures (70-75 °F, 21-24 °C), waiting for signs of fermentation, and then adjusting to the recommended temperature range for the strain. For higher gravities, we recommend increasing this pitching rate. This can be achieved by pitching additional Activator™ packages or by making a starter culture.